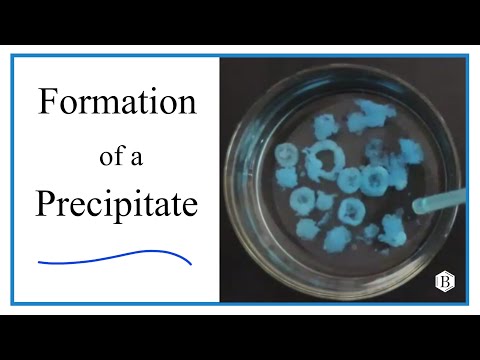

Index
All Exams >
Class 7 >
IGCSE Cambridge Science for Year 7 >
All Videos
All videos of IGCSE Cambridge Science for Year 7 for Class 7 Exam
Organisms and Cells
32 videos|61 docs|22 tests | Join course for free |
Structure and Properties of Material
Chemical Changes and Reactions
Electricity and Circuits
The Earth and Its Atmosphere
Video lectures for IGCSE Cambridge Science for Year 7 2025 is part of Class 7 exam preparation. The videos have been prepared according to the Class 7 exam syllabus. The Video lectures, notes, tests & MCQs are made for Class 7 2025 Exam. Find important definitions, questions, notes, meanings, examples, exercises, MCQs and online tests here.
Video lectures of IGCSE Cambridge Science for Year 7 in English & Hindi are available as part of Class 7 exam.
Download more important topics, notes, lectures and mock test series for Class 7 Exam by signing up for free.

Contact Support
Our team is online on weekdays between 10 AM - 7 PM
Typical reply within 3 hours
|
Free Exam Preparation
at your Fingertips!
Access Free Study Material - Test Series, Structured Courses, Free Videos & Study Notes and Prepare for Your Exam With Ease

 Join the 10M+ students on EduRev
Join the 10M+ students on EduRev
|

|
Create your account for free
OR
Forgot Password
OR
Signup on EduRev and stay on top of your study goals
10M+ students crushing their study goals daily